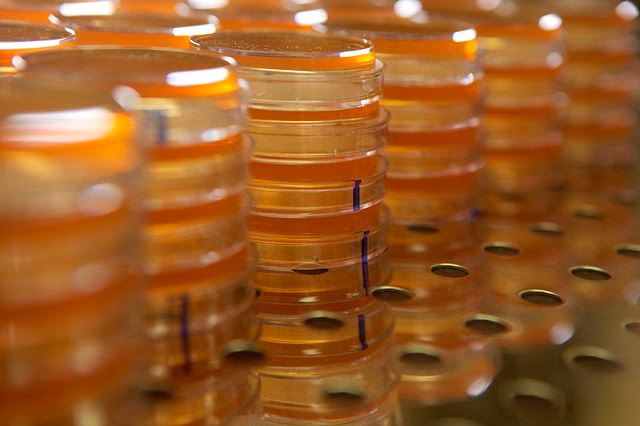
What is contamination testing & detection & analysis?

23/09/2019
En el corazón de la lucha por un planeta más sano y sostenible, existe una disciplina científica que actúa como un detective silencioso: el análisis de contaminación. A menudo asociado exclusivamente con procesos industriales y control de calidad, su verdadero alcance es mucho más profundo y vital para la salud de nuestros ecosistemas. Cada partícula, fibra o residuo químico que se escapa de un proceso de fabricación tiene el potencial de convertirse en una amenaza para el medio ambiente. Este artículo profundiza en el mundo del análisis, detección e identificación de contaminantes, no como un mero trámite industrial, sino como una herramienta fundamental para la protección ambiental y la prevención de desastres ecológicos.
Cuando un producto se contamina, las consecuencias van más allá de un fallo en su rendimiento o un riesgo para el consumidor. Esos mismos contaminantes pueden lixiviarse en vertederos, evaporarse en la atmósfera o ser arrastrados por la lluvia hacia ríos y océanos, iniciando una cadena de impacto negativo. Por ello, comprender y aplicar rigurosamente las técnicas de análisis de contaminación es una responsabilidad que trasciende las paredes de la fábrica, convirtiéndose en un pilar de la mayordomía ambiental.
¿Qué es el Análisis de Contaminación y por qué es Crucial para el Medio Ambiente?
El análisis de contaminación es un conjunto de procedimientos científicos diseñados para detectar, aislar, identificar y cuantificar sustancias extrañas y no deseadas en un producto, proceso o entorno. Desde una perspectiva ecológica, es el primer frente de batalla para evitar que los subproductos de la actividad humana dañen el mundo natural. Un problema de contaminación no controlado en una planta de producción puede parecer un asunto interno, pero sus repercusiones son globales. Puede amenazar la seguridad de un ecosistema, alterar el delicado equilibrio de la vida silvestre y, en última instancia, afectar la salud humana.

La contaminación es impredecible y puede manifestarse de innumerables formas: partículas microscópicas de metales pesados, fibras sintéticas, impurezas químicas, productos de degradación, residuos de catalizadores, entre otros. Estas sustancias pueden originarse en fuentes inesperadas y viajar grandes distancias. El análisis estratégico y rápido es clave para identificar la naturaleza del contaminante, determinar su origen y aplicar una solución antes de que el daño sea irreversible. Actúa como un sistema de alerta temprana, permitiendo una intervención proactiva en lugar de una reacción tardía a una crisis ambiental ya desatada.
Los Contaminantes Invisibles: Un Enemigo Silencioso
Muchos de los contaminantes más peligrosos son invisibles a simple vista. Se requiere tecnología avanzada y experiencia para detectarlos en niveles de trazas o ultra-trazas. Estos enemigos silenciosos pueden estar presentes en líquidos, sólidos, gases, polvos y superficies, abarcando materiales orgánicos e inorgánicos.
- Partículas y Fibras: Pueden ser desde virutas metálicas hasta microplásticos. En el medio ambiente, se convierten en contaminantes del aire que afectan la salud respiratoria o en contaminantes del agua que son ingeridos por la fauna marina, introduciéndose en la cadena alimentaria.
- Metales Pesados: Elementos como el plomo, mercurio o cadmio son altamente tóxicos. El análisis preciso, como la espectrometría, es crucial para detectarlos en productos de consumo y evitar que terminen en vertederos, donde pueden contaminar el suelo y las aguas subterráneas durante siglos.
- Impurezas Químicas: Residuos de disolventes, productos de reacción o agentes de limpieza pueden ser tóxicos para la vida acuática, causar eutrofización en cuerpos de agua o degradar la calidad del suelo, afectando la agricultura y los hábitats naturales. La prevención mediante un riguroso control es la mejor estrategia.
El Laboratorio: El Escudo Científico Contra la Polución
Los laboratorios de análisis de contaminación son el epicentro de esta labor de protección. Utilizan un arsenal de técnicas analíticas avanzadas para desentrañar la composición química de las sustancias más complejas. La elección del método depende del tipo de material a analizar y la naturaleza de la contaminación sospechada. A continuación, se describen algunas de las técnicas más poderosas y su relevancia ambiental.

Técnicas Clave en la Detección de Contaminantes
FTIR (Espectroscopía de Infrarrojos por Transformada de Fourier): Esta es la técnica de referencia para identificar contaminantes orgánicos no metálicos como aceites, grasas, plásticos y cauchos. Funciona proyectando luz infrarroja sobre una muestra y midiendo la luz que absorbe. Cada compuesto químico tiene una "huella dactilar" de absorción única, lo que permite una identificación precisa. En términos ambientales, es fundamental para identificar derrames de hidrocarburos, contaminación por microplásticos o residuos de pesticidas.
SEM/EDS (Microscopía Electrónica de Barrido con Espectroscopía de Rayos X de Energía Dispersiva): Esta técnica combina un microscopio de alta potencia con un análisis elemental. Permite no solo visualizar partículas contaminantes a un nivel de aumento extremo, sino también determinar de qué elementos químicos están compuestas. Es ideal para analizar partículas metálicas, polvo industrial o cualquier contaminante sólido, ayudando a rastrear el origen de la polución atmosférica o del suelo.
ICP/AES (Espectrometría de Emisión Atómica con Plasma de Acoplamiento Inductivo): Es un método increíblemente flexible y sensible para el análisis de elementos traza, especialmente metales pesados. La muestra se introduce en un plasma a altísima temperatura, lo que hace que los átomos emitan luz en longitudes de onda características. Midiendo esta luz, se puede determinar la composición elemental de la muestra con una precisión de partes por millón (ppm). Es la herramienta estándar para verificar la ausencia de plomo en productos de consumo y para el monitoreo de la calidad del agua y el suelo.

IC (Cromatografía Iónica): Especializada en la detección de partículas cargadas (iones). Es extremadamente eficaz para identificar y cuantificar aniones comunes como cloruros, nitratos, nitritos y sulfuros. Estos iones, además de ser contaminantes generales, pueden ser precursores de la corrosión y, en el medio ambiente, son los principales responsables de la lluvia ácida y la eutrofización de lagos y ríos, que provoca la proliferación de algas y la muerte de la vida acuática.
Tabla Comparativa de Técnicas Analíticas
| Técnica Analítica | ¿Qué Detecta? | Relevancia Ambiental Primaria |
|---|---|---|
| FTIR | Compuestos orgánicos (plásticos, aceites, grasas, pesticidas). | Identificación de microplásticos y derrames de hidrocarburos. |
| SEM/EDS | Partículas sólidas y su composición elemental. | Análisis de polvo atmosférico y contaminantes del suelo. |
| ICP/AES | Metales pesados y otros elementos en trazas. | Monitoreo de la calidad del agua potable y suelos agrícolas. |
| IC | Iones disueltos (nitratos, sulfatos, cloruros). | Control de la contaminación del agua (lluvia ácida, eutrofización). |
Normativas y Limpieza Técnica: La Conexión Industrial-Ecológica
Estándares como la ISO 16232 o la VDA 19, aunque nacieron en el seno de la industria automotriz para garantizar la fiabilidad de los componentes, tienen un profundo impacto ecológico. Estos marcos establecen métodos rigurosos para evaluar y controlar la contaminación por partículas. Al obligar a los fabricantes a mantener sus procesos y componentes extremadamente limpios, indirectamente reducen la cantidad de contaminantes que podrían liberarse al medio ambiente. La "limpieza técnica" va más allá de una inspección superficial; es una filosofía de producción que minimiza la generación de residuos en su origen.
Este enfoque preventivo es mucho más eficaz y económico que remediar un problema de contaminación ya existente. Asegurar la limpieza a nivel microscópico en una línea de montaje se traduce en menos partículas dañinas en el aire de las ciudades, menos metales tóxicos en nuestros ríos y menos residuos plásticos en los océanos. La trazabilidad y el control en cada etapa del proceso productivo son, por tanto, herramientas indirectas pero poderosas de conservación ambiental.

Preguntas Frecuentes (FAQ)
¿Por qué es importante analizar contaminantes que no se ven a simple vista?
Porque los contaminantes más peligrosos suelen ser microscópicos. Partículas de metales pesados o moléculas de productos químicos tóxicos pueden bioacumularse en la cadena alimentaria y causar daños graves a la salud de los ecosistemas y de los seres humanos, incluso en concentraciones muy bajas. La detección temprana es la única forma de prevenir estos impactos a largo plazo.
¿Un producto "limpio" de fábrica garantiza que no contamina el medio ambiente?
No necesariamente, pero reduce drásticamente el riesgo. Un producto fabricado bajo estrictos controles de limpieza técnica tendrá menos contaminantes que puedan liberarse durante su uso o al final de su vida útil. Sin embargo, el diseño del producto, los materiales utilizados y su correcta gestión como residuo son igualmente importantes para determinar su impacto ambiental total.
¿Qué papel juegan las normativas como la ISO en la protección ambiental?
Juegan un papel fundamental al establecer un lenguaje y unos métodos comunes para el control de la calidad y la limpieza. Al estandarizar las mejores prácticas, promueven una cultura de prevención que beneficia directamente al medio ambiente. Obligan a las industrias a ser más conscientes de sus procesos y a minimizar la generación de residuos y contaminantes, lo que se conoce como "Producción Más Limpia".

¿Cómo se realiza el muestreo para un análisis ambiental?
El muestreo, o la recolección de muestras, es un paso crítico. Para el monitoreo ambiental, se utilizan técnicas similares a las industriales pero adaptadas al entorno. Se pueden usar hisopos especiales (swabs) para tomar muestras de superficies de hojas o rocas, recipientes estériles para recoger muestras de agua de un río, o equipos de succión para capturar partículas del aire. La clave es obtener una muestra representativa que refleje con precisión el estado del entorno que se está estudiando.
En conclusión, el análisis de contaminación es mucho más que una simple herramienta de control de calidad industrial. Es una ciencia de vanguardia que sirve como guardián de la salud de nuestro planeta. Al detectar y cuantificar las amenazas invisibles antes de que causen un daño generalizado, los químicos y técnicos analíticos se convierten en protectores de primera línea de nuestros ecosistemas. Apoyar y exigir procesos de producción más limpios y transparentes, respaldados por análisis científicos rigurosos, es un paso esencial hacia un futuro en el que la actividad industrial y la salud ambiental puedan coexistir en armonía.
Si quieres conocer otros artículos parecidos a Análisis de Contaminación: Protegiendo Ecosistemas puedes visitar la categoría Contaminación.
